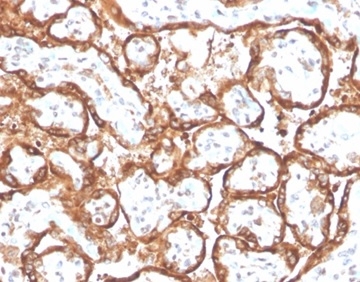
Chorionic Gonadotropin alpha Chain (hCG alpha) Antibody (HCGa/2728R) - Azide and BSA Free

294 results for "Chorionic Gonadotropin alpha Chain (HCG alpha)" in Products
Chorionic Gonadotropin alpha Chain (HCG alpha) Products
HCG is a glycoprotein hormone secreted in pregnancy by embryonic trophoblast cells during the first 7 weeks of gestation. Production subsequently shifts to the placenta, where it continues until term. HCG is a heterodimer consisting of an alpha chain and a beta chain. The alpha chain is common to several other hormones, including lutenizing hormone (LH), follicle stimulating hormone (FSH), and thyroid stimulating hormone (TSH), while the beta chain is unique to HCG. Both alpha and beta chains contain a cysteine knot motif, also found in growth factors such as TGF-beta family members.
| Reactivity: | Human |
| Details: | Rabbit IgG Polyclonal |
| Applications: | Secondary |
| Reactivity: | Human |
| Details: | Rabbit IgG Polyclonal |
| Applications: | Secondary |
| Reactivity: | Human |
| Details: | Rabbit IgG Polyclonal |
| Applications: | Secondary |
| Reactivity: | Human |
| Details: | Rabbit IgG Polyclonal |
| Applications: | Secondary |
| Reactivity: | Human |
| Details: | Rabbit IgG Polyclonal |
| Applications: | Secondary |
| Reactivity: | Human |
| Details: | Rabbit IgG Polyclonal |
| Applications: | Secondary |
| Reactivity: | Human |
| Details: | Rabbit IgG Polyclonal |
| Applications: | Secondary |
| Reactivity: | Human |
| Details: | Rabbit IgG Polyclonal |
| Applications: | Secondary |
| Reactivity: | Human |
| Details: | Rabbit IgG Polyclonal |
| Applications: | Secondary |
| Reactivity: | Human |
| Details: | Mouse IgG Monoclonal Clone #INN-hCG-5 |
| Applications: | IHC, WB, Func |
| Reactivity: | Human |
| Details: | Mouse IgG1 Monoclonal Clone #INN-hFSH-132 |
| Applications: | IHC, WB, ELISA, IP |
| Reactivity: | Human |
| Details: | Rabbit IgG Polyclonal |
| Applications: | IHC |
| Reactivity: | Human |
| Details: | Mouse IgG1 Monoclonal Clone #INN-hFSH-132 |
| Applications: | IHC, WB, ELISA, IP |
| Reactivity: | Human |
| Details: | Goat IgG Polyclonal |
| Applications: | IHC, WB, ELISA, DB |
| Reactivity: | Human |
| Details: | Mouse IgG1 Monoclonal Clone #2E6B3 |
| Applications: | WB, ELISA |
Recombinant Monoclonal Antibody
| Reactivity: | Human |
| Details: | Rabbit IgG Monoclonal Clone #RM330 |
| Applications: | IHC, WB, ELISA |
| Reactivity: | Human |
| Details: | Mouse IgG1 kappa Monoclonal Clone #HCGa/53 |
| Applications: | IHC |
| Reactivity: | Human |
| Details: | Mouse IgG1 kappa Monoclonal Clone #LHa/756 |
| Applications: | IHC |
| Reactivity: | Human |
| Details: | Mouse IgG1 kappa Monoclonal Clone #SPM552 |
| Applications: | IHC |
Recombinant Monoclonal Antibody
| Reactivity: | Human |
| Details: | Rabbit IgG Kappa Monoclonal Clone #HCGa/2728R |
| Applications: | IHC |
| Reactivity: | Human |
| Details: | Mouse IgG1 kappa Monoclonal Clone #SPM552 |
| Applications: | IHC |
| Reactivity: | Human |
| Details: | Mouse IgG1 kappa Monoclonal Clone #SPM552 |
| Applications: | IHC |
Recombinant Monoclonal Antibody
| Reactivity: | Human |
| Details: | Rabbit IgG Kappa Monoclonal Clone #HCGa/2728R |
| Applications: | IHC |
| Applications: | AC |
| Applications: | ELISA |



![Immunohistochemistry-Paraffin: Chorionic Gonadotropin alpha Chain (hCG alpha) Antibody [NBP2-34183] Immunohistochemistry-Paraffin: Chorionic Gonadotropin alpha Chain (hCG alpha) Antibody [NBP2-34183]](https://resources.bio-techne.com/images/products/Chorionic-Gonadotropin-alpha-Chain-hCG-alpha-Antibody-Immunohistochemistry-Paraffin-NBP2-34183-img0005.jpg)
![Western Blot: Chorionic Gonadotropin alpha Chain (hCG alpha) Antibody [NBP3-18630] Western Blot: Chorionic Gonadotropin alpha Chain (hCG alpha) Antibody [NBP3-18630]](https://resources.bio-techne.com/images/products/Chorionic-Gonadotropin-alpha-Chain-hCG-alpha-Antibody-Western-Blot-NBP3-18630-img0002.jpg)
![Western Blot: Chorionic Gonadotropin alpha Chain (hCG alpha) Antibody (2E6B3)BSA Free [NBP2-52442] Western Blot: Chorionic Gonadotropin alpha Chain (hCG alpha) Antibody (2E6B3)BSA Free [NBP2-52442]](https://resources.bio-techne.com/images/products/Chorionic-Gonadotropin-alpha-Chain-HCG-alpha-Antibody-2E6B3-Western-Blot-NBP2-52442-img0001.jpg)
![Western Blot: Chorionic Gonadotropin alpha Chain (hCG alpha) Antibody (RM330) [NBP2-77412] Western Blot: Chorionic Gonadotropin alpha Chain (hCG alpha) Antibody (RM330) [NBP2-77412]](https://resources.bio-techne.com/images/products/Chorionic-Gonadotropin-alpha-Chain-hCG-alpha-Antibody-RM330-Western-Blot-NBP2-77412-img0002.jpg)
![Immunohistochemistry-Paraffin: Chorionic Gonadotropin alpha Chain (hCG alpha) Antibody (HCGa/53) - IHC-Prediluted [NBP2-45135] Immunohistochemistry-Paraffin: Chorionic Gonadotropin alpha Chain (hCG alpha) Antibody (HCGa/53) - IHC-Prediluted [NBP2-45135]](https://resources.bio-techne.com/images/products/Chorionic-Gonadotropin-alpha-Chain-hCG-alpha-Antibody-HCGa-53-IHC-Prediluted-Immunohistochemistry-Paraffin-NBP2-45135-img0001.jpg)
![Immunohistochemistry-Paraffin: Chorionic Gonadotropin alpha Chain (hCG alpha) Antibody (LHa/756) [NBP2-53394] Immunohistochemistry-Paraffin: Chorionic Gonadotropin alpha Chain (hCG alpha) Antibody (LHa/756) [NBP2-53394]](https://resources.bio-techne.com/images/products/Chorionic-Gonadotropin-alpha-Chain-hCG-alpha-Antibody-LHa-756-Immunohistochemistry-Paraffin-NBP2-53394-img0001.jpg)
![Immunohistochemistry-Paraffin: Chorionic Gonadotropin alpha Chain (hCG alpha) Antibody (SPM552) [NBP2-32971] Immunohistochemistry-Paraffin: Chorionic Gonadotropin alpha Chain (hCG alpha) Antibody (SPM552) [NBP2-32971]](https://resources.bio-techne.com/images/products/Chorionic-Gonadotropin-alpha-Chain-hCG-alpha-Antibody-SPM552-Immunohistochemistry-Paraffin-NBP2-32971-img0001.jpg)
![Immunohistochemistry-Paraffin: Chorionic Gonadotropin alpha Chain (hCG alpha) Antibody (SPM552) - Azide and BSA Free [NBP2-34794] Immunohistochemistry-Paraffin: Chorionic Gonadotropin alpha Chain (hCG alpha) Antibody (SPM552) - Azide and BSA Free [NBP2-34794]](https://resources.bio-techne.com/images/products/Chorionic-Gonadotropin-alpha-Chain-hCG-alpha-Antibody-SPM552-Azide-and-BSA-Free-Immunohistochemistry-Paraffin-NBP2-34794-img0001.jpg)
![Immunohistochemistry-Paraffin: Chorionic Gonadotropin alpha Chain (hCG alpha) Antibody (SPM552) - IHC-Prediluted [NBP2-45136] Immunohistochemistry-Paraffin: Chorionic Gonadotropin alpha Chain (hCG alpha) Antibody (SPM552) - IHC-Prediluted [NBP2-45136]](https://resources.bio-techne.com/images/products/Chorionic-Gonadotropin-alpha-Chain-hCG-alpha-Antibody-SPM552-IHC-Prediluted-Immunohistochemistry-Paraffin-NBP2-45136-img0001.jpg)
![Immunohistochemistry-Paraffin: Chorionic Gonadotropin alpha Chain (hCG alpha) Antibody (HCGa/2728R) [NBP3-13844] Immunohistochemistry-Paraffin: Chorionic Gonadotropin alpha Chain (hCG alpha) Antibody (HCGa/2728R) [NBP3-13844]](https://resources.bio-techne.com/images/products/Chorionic-Gonadotropin-alpha-Chain-hCG-alpha-Antibody-HCGa-2728R-Immunohistochemistry-Paraffin-NBP3-13844-img0001.jpg)
![ELISA: Human Chorionic Gonadotropin alpha Chain (hCG alpha) ELISA Kit (Colorimetric) [NBP2-75262] - Human Chorionic Gonadotropin alpha Chain (hCG alpha) ELISA Kit (Colorimetric)](https://resources.bio-techne.com/images/products/nbp2-75262_human-chorionic-gonadotropin-alpha-chain-elisa-kit-13220241610229.jpg)